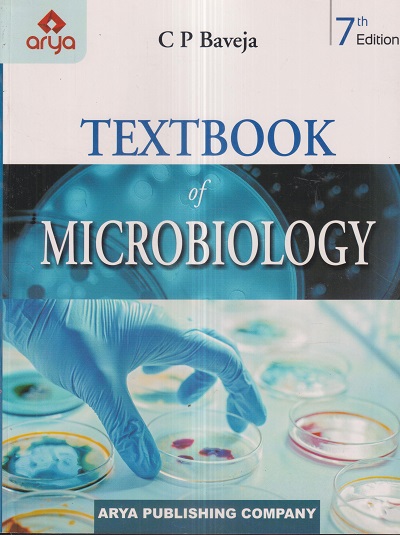
TEXTBOOK OF MICROBIOLOGY | C.P. BAVEJA | Arya Publishing Company

Books for Medical PG Entrance Exam
86 titles found

NEW (15%)
COMPLETE MICROBIOLOGY For MBBS (Free Practical Microbiology For MBBS) | C.P. BAVEJA, V. BAVEJA | Avichal Publishing Company/Arya Publishing Company
NEW (15%)
TEXTBOOK OF MICROBIOLOGY | C.P. BAVEJA | Arya Publishing Company

NEW (30%)
A COMPLETE NEXT CENTRIC APPROACH FMGE SOLUTIONS | DEEPAK MARWAH, SIRAJ AHMAD | CBS

NEW (25%)
REVIEW OF PATHOLOGY AND GENETICS | GOBIND RAI GARG, SPARSH GUPTA | Jaypee
MEDICAL PG

NEW (25%)
TEXTBOOK OF ANATOMY (Abdomen And Lower Limb) Vol. II | VISHRAM SINGH | Elsevier

NEW (10%)
आरोग्य विभाग संपूर्ण तांत्रिक ठोकळा | वर्षा पब्लिकेशन (Varsha Publication)
Health Department

NEW (15%)
SURGERY FOR PGMEE | ASHISH GUPTA, AMIT TRIPATHI | Pulse
9789380438900 | Medicine and Allied Health Sciences Books | Books for Medical PG Entrance Exam

NEW (15%)
SELF ASSESSMENT AND REVIEW OF PATHOLOGY | ARVIND ARORA | Pulse
9789385722066 | Medicine and Allied Health Sciences Books | Books for Medical PG Entrance Exam

NEW (15%)
SELF ASSESSMENT AND REVIEW OF MICROBIOLOGY | ARVIND ARORA | Pulse
9788194087816 | Medicine and Allied Health Sciences Books | Books for Medical PG Entrance Exam

NEW (15%)
SELF ASSESSMENT AND REVIEW OF PHARMACOLOGY | ARVIND ARORA | Pulse
9789385722943 | Medicine and Allied Health Sciences Books | Books for Medical PG Entrance Exam

NEW (15%)
SELF ASSESSMENT AND REVIEW OF PAEDIATRICS | ARVIND ARORA | Pulse
9789385722820 | Medicine and Allied Health Sciences Books | Books for Medical PG Entrance Exam

NEW (15%)
SELF ASSESSMENT AND REVIEW OF PREVENTIVE AND SOCIAL MEDICINE | ARVIND ARORA | Pulse
9789385722073 | Medicine and Allied Health Sciences Books | Books for Medical PG Entrance Exam
